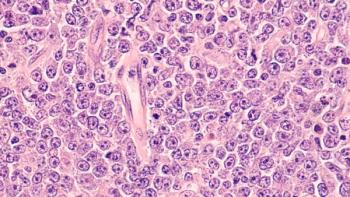

Providers
Latest News

Latest Videos

CME Content
More News

A recent study suggests that patients with high-risk prostate cancer (PCa) in need of renal transplantation should receive cancer treatment before their transplants, as surgery and radiation treatment for localized PCa appear to be equally effective in this patient population.

The number one ingredient that an oncology-based alternative payment model needs to succeed is collaboration, explained Nicolas Ferreyros, managing director of policy, advocacy, and communications, Community Oncology Alliance (COA).

Data from fee-for-service Medicare claims that were linked to the Surveillance, Epidemiology, and End Results program were used for this retrospective cohort analysis among women 70 years and older.

Researchers conducted a cohort study that suggests oral N-acetylglucosamine treatment can hinder neurodegeneration and inflammation associated with multiple sclerosis (MS).

In just the last 2 years there have been updates in classification, risk assessment, and response criteria in myelodysplastic syndromes (MDS), but additional efforts are needed to improve these, and there remains a need for better therapies.

Elevated serum endotrophin levels, but not urinary endotrophin levels, predict increased risk of kidney complications and mortality in type 1 diabetes.

Findings showed that autonomic symptom burden was slightly more severe in patients with multiple sclerosis (MS) compared with those with NMOSD, although the difference was not statistically significant.

Data from 6 states—California, Florida, Louisiana, New Jersey, North Carolina, and Pennsylvania—and 2 metropolitan areas—Atlanta, Georgia, and Detroit, Michigan—collected through the National Institutes of Health–AARP Diet and Health Study were used for the investigation.

In a retrospective, real-world cohort study, the factors complicating the diagnosis of primary progressive forms of multiple sclerosis (PPMS) were explored.

Self-care adherence, family support and functioning, and school support also indirectly affected the relationship between sociodemographic and clinical variables and metabolic control, a study found.

The measure of total DNA in leukemic cells as defined by a DNA index outperformed other criteria for identifying patients with hyperdiploid acute lymphoblastic leukemia (ALL) and favorable prognosis.

Among adults 40 years and older with chronic obstructive pulmonary disease (COPD), there is a higher prevalence of cardiovascular diseases (CVDs) compared with a general population without COPD.

Researchers found that analyzing certain chemokine levels may help explain racial disparities in prostate cancer lethality, and that neutralizing such chemokines could potentially benefit prostate cancer treatment.

Salvage radiation therapy (RT) showed efficacy in local control of relapsed or refractory large B-cell lymphoma (LBCL) following CD19-targeted chimeric antigen receptor (CAR) T-cell therapy failure.

A survey of gastroenterologists, dermatologists, and rheumatologists found Amjevita had the most recognition, followed by Cyltezo, the only interchangeable biosimilar on the US market.

Public health professionals are the backbone of our health system, and their contributions are vital to the well-being of our communities. As a society, we must value their work, provide the support they need, and ensure that public health remains a rewarding and viable career choice.

Several discrepancies in care must be considered to properly address psychological needs in patients with lymphoma, including patient/doctor communication, information provision, and applying distress guidelines.

"CMS cannot do this alone. We have to do this in partnership. So really thinking about providers and beneficiaries and how we do this together," Ellen Lukens, MPH, Center for Medicare and Medicaid Innovation, explained.

Persistent disability and risks of death were associated with inflammatory levels in patients following major abdominal surgery.

A tailored electronic health record (EHR) alert system did not significantly increase the prescription of guideline-directed medical therapies (GDMT) at hospital discharge for patients with acute heart failure (AHF).

Kristin Oaks, DO, Agilon regional medical director at Central Ohio Primary Care, spoke at our recent Institute for Value-Based Medicine® event held with Zangmeister Cancer Center. Here, she addresses the importance of value-based care within the primary care space.
Subcutaneous epcoritamab produced deep and durable complete remissions in patients with relapsed or refractory (R/R) large B-cell lymphoma (LBCL), with complete responders having favorable long-term outcomes, according to updated data from the phase 1/2 EPCORE NHL-1 trial.

Patients now have higher expectations of us health care professionals, and we have to meet those expectations, said Donna Fitzsimons, PhD, FESC, professor of nursing at the School of Nursing and Midwifery, Queen's University Belfast.

In a real-world study using data from patients diagnosed with multiple myeloma between 2009 and 2021, second primary malignancies adversely impacted survival outcomes in the modern era of therapeutics.

Researchers add to evidence suggesting that inflammatory factors contribute to increased risk for valvular heart diseases, such as aortic stenosis, in patients with rheumatoid arthritis.